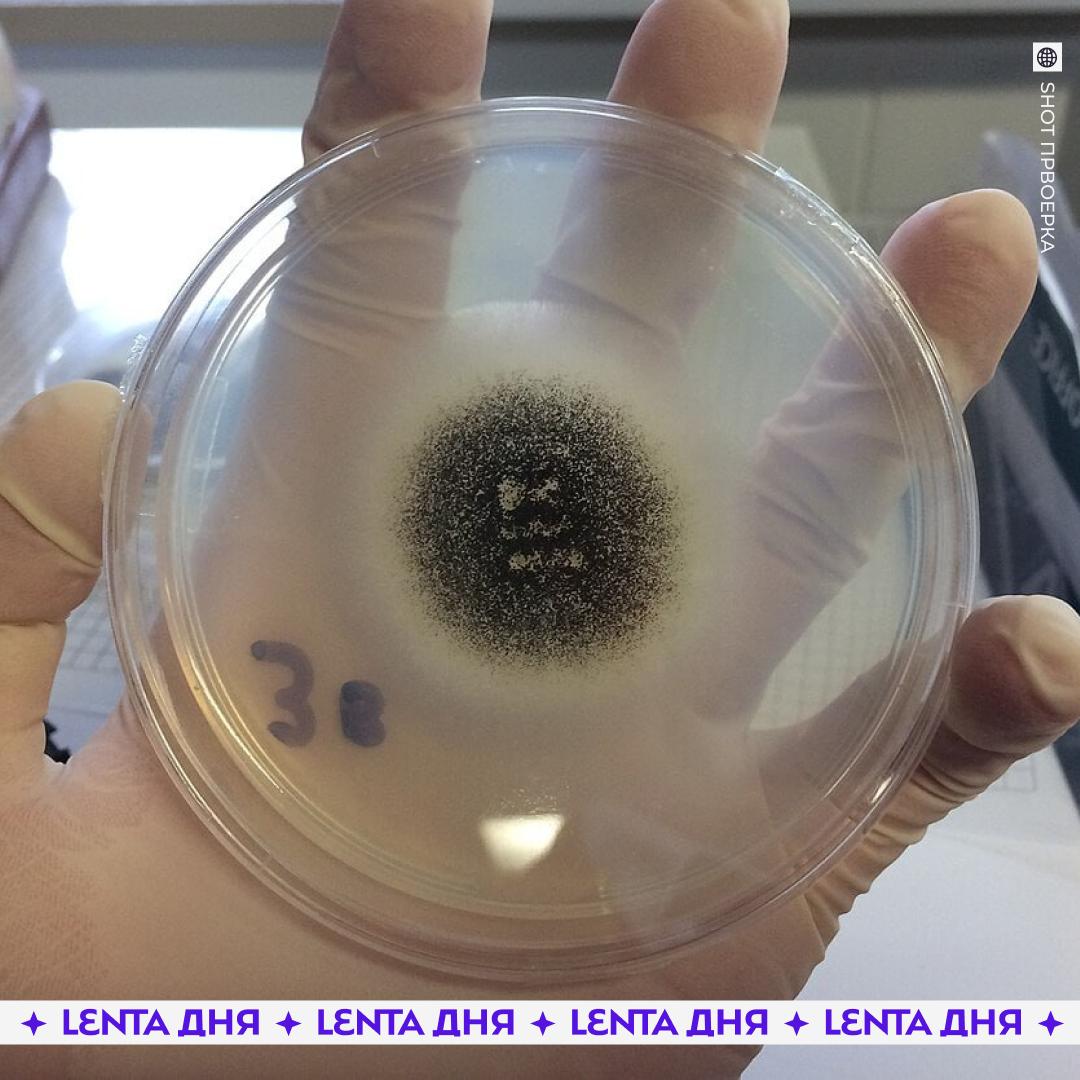
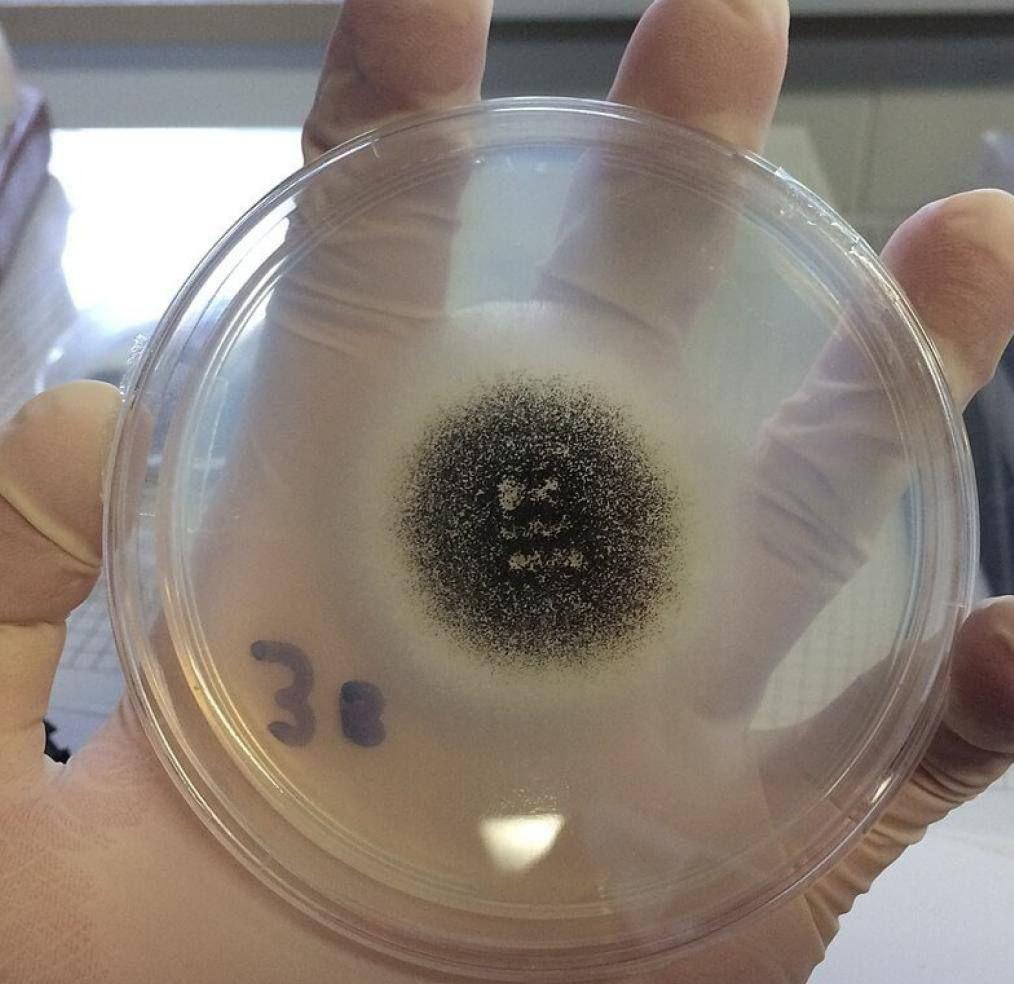
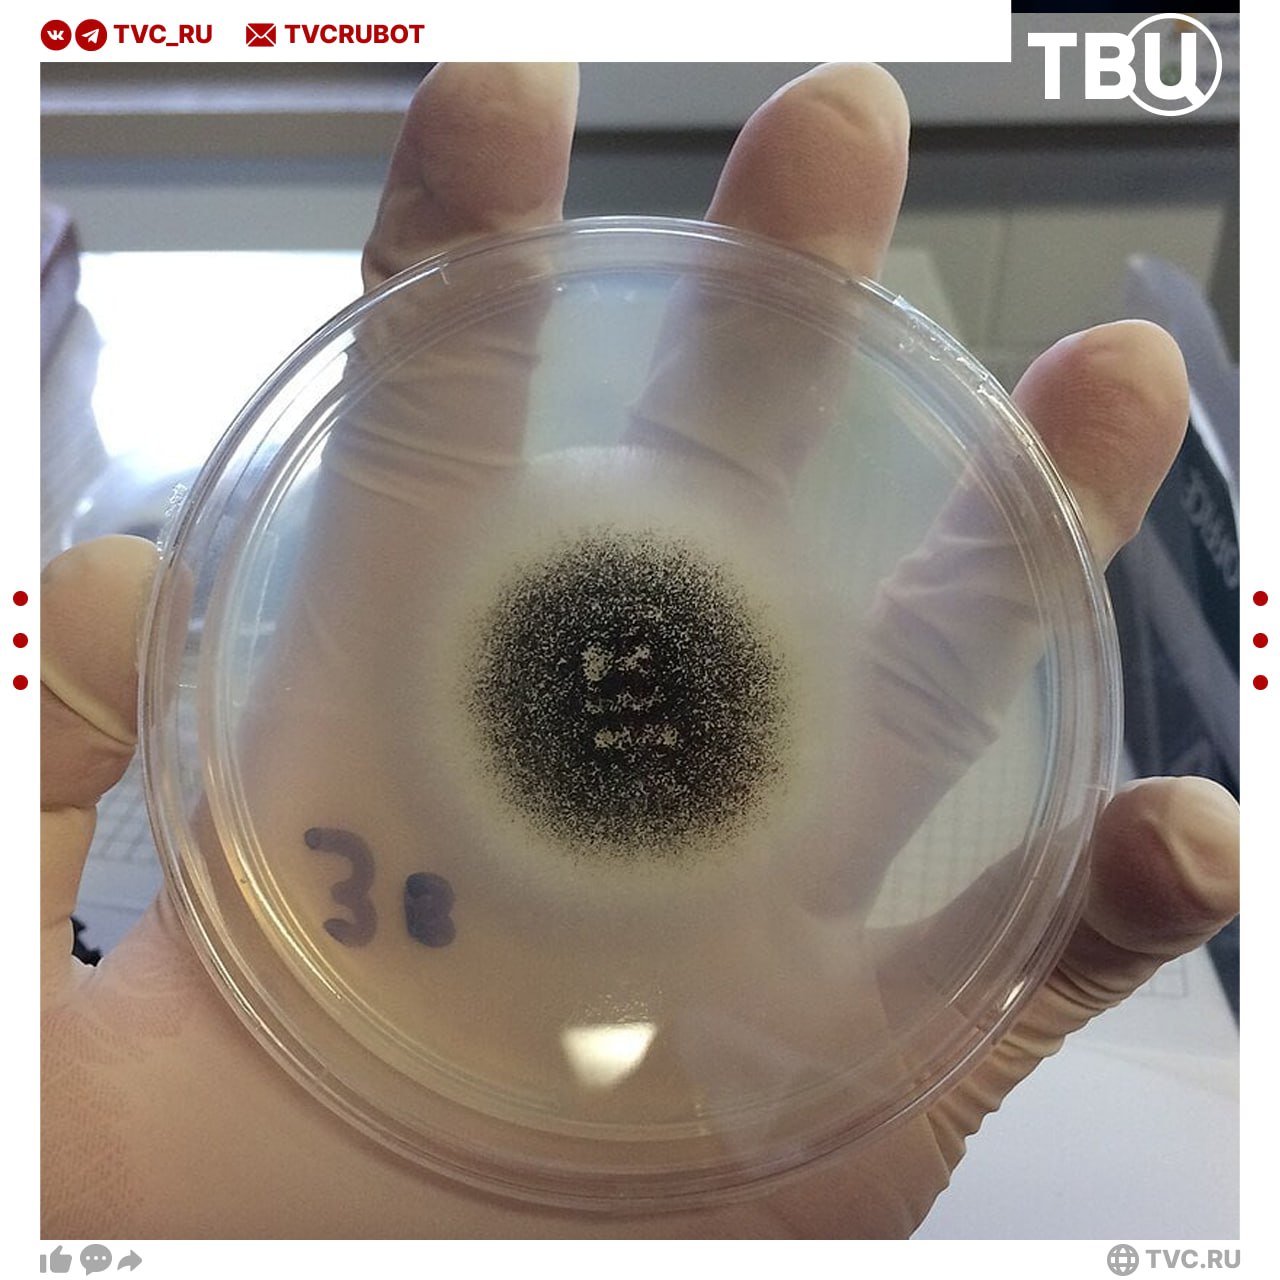
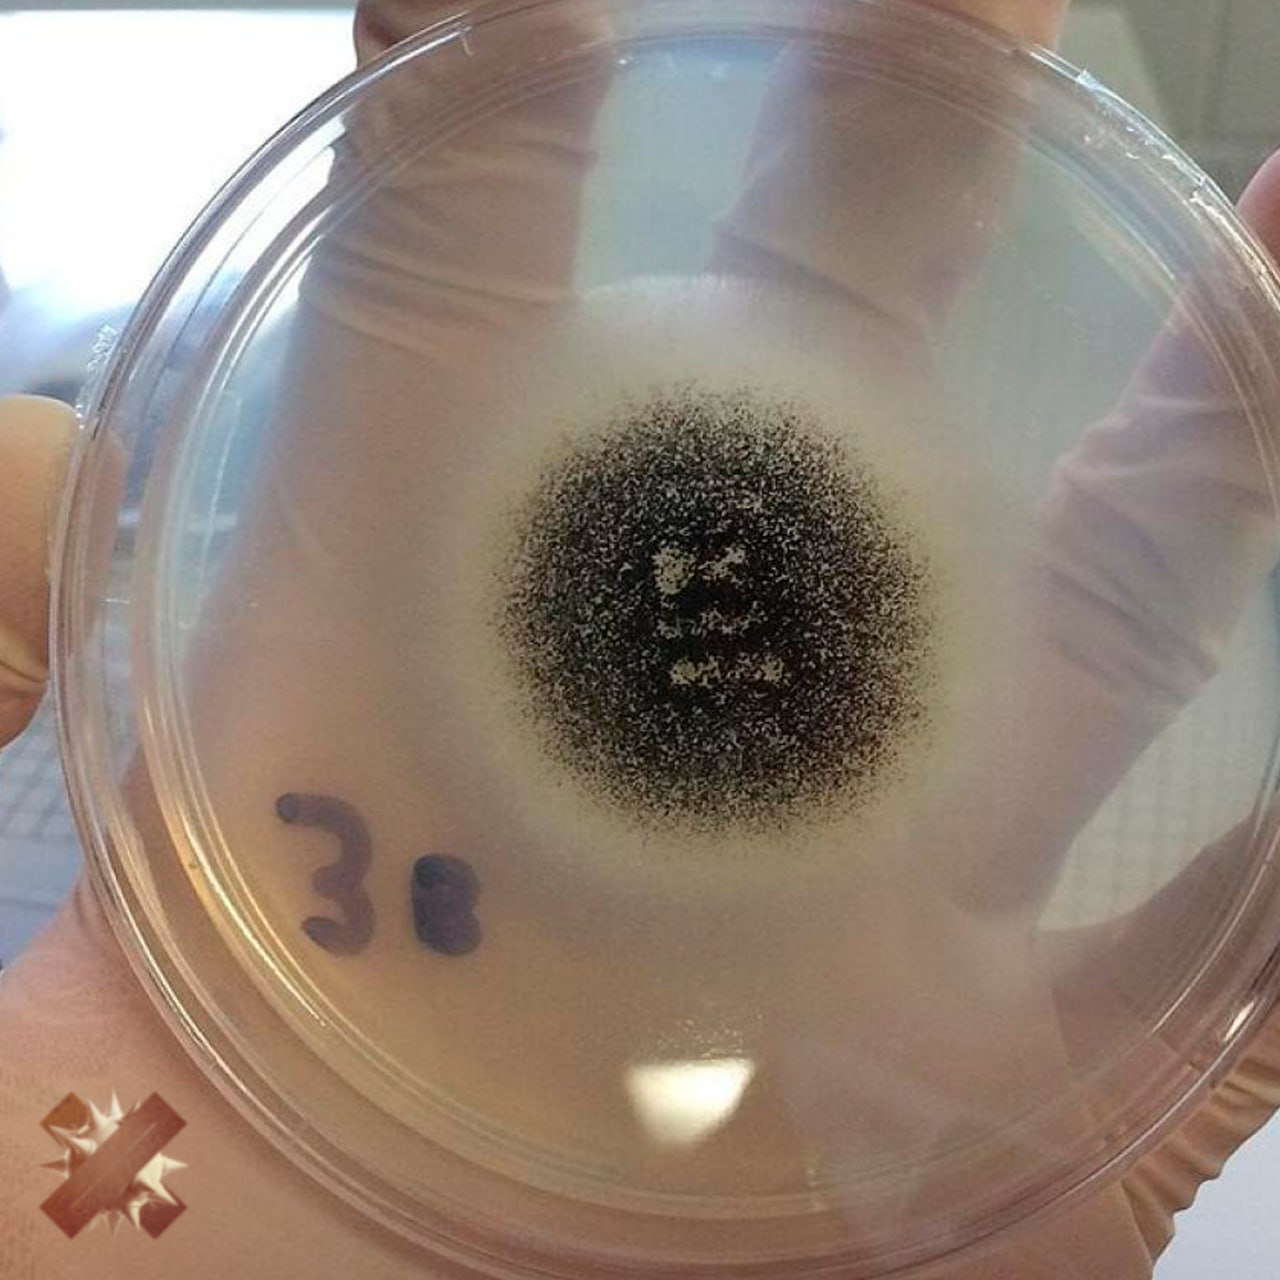

20 октября, 14:19
Россиянка столкнулась с аллергическим аспергиллезом после отдыха в Турции

Лента дня
Плесень завелась в лёгких россиянки после отдыха в Турции Два месяца назад девушка вернулась с отдыха с постоянным сильным сухим кашлем и насморком который она списывала на ОРВИ а затем на бронхит Со временем самочувствие только ухудшалось появилась боль в боку и под грудью Пациентка потратила более 100 тысяч рублей на проверки В итоге у неё выявили аллергический аспергиллёз вызванный смертельно опасными грибками а в анализах нашли дрожжевой грибок и бактерии Сейчас она продолжает лечиться от страшного заболевания Подпишись на Ленту дня MAX ТГ Участвуй в розыгрыше
Происшествия2 дня назад


Москва 24
Трэш Россиянка вернулась с отдыха в Турции со смертельно опасной плесенью в лёгких Женщину мучили сильный сухой кашель и насморк По данным SHOT сначала её лечили от ОРВИ ухудшение состояния списали на бронхит Почти два месяца она моталась по клиникам пытаясь понять почему не получается выздороветь И вот в одной из них после допобследований удалось докопаться до истинной причины У пациентки нашли аспергиллёз осложнённый кандидозом дыхательных путей Это такая инфекция которую вызывают плесневые грибы рода Aspergillus Также в пробах обнаружили дрожжевой грибок Сейчас женщина уже получает лечение Подписаться на Москва 24 Наши каналы Новости в MAX
Происшествия2 дня назад

The Экономист
У россиянки после отдыха в Турции появилась плесень в лёгких сообщает Shot Два месяца она лечилась от кашля насморка и боли в боку потратив 100 тыс рублей на проверки The Экономист
Происшествия2 дня назад

Москва сейчас
Плесень в легких появилась у россиянки после отдыха в Турции Девушке пришлось два месяца она лечиться от кашля насморка и боли в боку сообщает Shot На анализы она потратила 100 тыс рублей Москва сейчас Подписаться Прислать новость
Происшествия2 дня назад

В Туризме | Медиа про путешествия
Россиянка после отдыха в Турции подхватила грибковую инфекцию лёгких Два месяца её мучили кашель и насморк появились боли в груди На обследования ушло около 100 тысяч рублей Диагноз аллергический аспергиллёз инфекция развивается из за плесневых грибков которые попадают в лёгкие через воздух во влажных помещениях и пыльных зонах
Происшествия1 день назад


Радиоточка НСН
Опасная плесень Опасную плесень начали выявлять в легких россиян после отдыха в Турции Сразу после отпуска на турецком курорте у девушки начался сильный сухой кашель Россиянка забила на лечение и списала все на обычную простуду Через два месяца ее состояние резко ухудшилось появились боли в груди врачи нашли в ее легких опасный грибок Aspergillus а в анализах дрожжевой грибок и бактерии которые вызывали острую аллергическую реакцию Врачи уверены что заразу она подцепила на отдыхе в Турции
Происшествия11 часов назад

ТВ Центр | ТВЦ
Опасную грибковую плесень нашли в легких россиянки После отдыха в Турции у девушки появился сухой кашель и насморк Спустя два месяца врачи поставили ей аллергический аспергиллёз который вызвал грибок в легких При этом пульмонолог Александр Пальман считает что подцепить такой грибок на курорте невозможно Мне кажется здесь совершенно случайное совпадение Она с таким же успехом могла отдыхать не в Турции а где нибудь еще Если человек живет в подвале с плесенью на стенах у него могут быть проблемы рассказал ТВЦ врач Подписаться на ТВЦ в MAX
Происшествия2 дня назад

НЕ МОРГЕНШТЕРН
После отдыха в Турции у россиянки в лёгких обнаружили плесень Девушка два месяца страдала от кашля и боли в груди думая что это обычное ОРВИ После множества обследований выяснилось что у неё аллергический аспергиллёз болезнь вызванная опасными грибками Она потратила свыше 100 000 на диагностику и продолжает лечение пусть выздоравливает в Турцию пока не ездим НЕ МОРГЕНШТЕРН
Происшествия2 дня назад

Карантини
После отпуска в Турции у россиянки обнаружили плесень в лёгких СМИ Два месяца она боролась с кашлем насморком и болью в боку потратив на обследования около 100 тысяч рублей Врачи в итоге диагностировали аллергический аспергиллёз заболевание вызванное опасными грибками
Происшествия1 день назад


Авдеевка.РУ🇷🇺
Смертельно опасную плесень нашли в легких россиянки после отдыха в Турции Болезнь развивалась незаметно в течение двух месяцев после возвращения домой После возвращения с отдыха в Турции у россиянки появились сильный сухой кашель и насморк которые со временем усиливались Спустя два месяца врачи нашли в ее легких смертельно опасные грибки рода Aspergillus Девушке поставили диагноз аллергический аспергиллез осложненный кандидозом дыхательных путей Болезнь вызывают опасные грибки рода Aspergillus Вдобавок к этому в анализах пациентки нашли дрожжевой грибок бактерии и аллергическую реакцию
Происшествия1 день назад

Похожие новости



+99



+15



+9



+8



+2



+5

Увеличение случаев кишечной инфекции в Бурятии связано с готовой едой
Происшествия
4 часа назад




Туристка с травмой позвоночника эвакуирована с Курильского озера
Происшествия
5 часов назад




Фельдшеры Ленобласти спасли синицу, попавшую в бедственное положение
Наука
4 часа назад




Ростовчанин выжил после трехнедельной реанимации из-за запущенного кариеса
Происшествия
2 часа назад




В Москве спасли упитанную летучую мышь по имени Пуговка
Наука
5 часов назад




Лисы привлекают внимание жителей Читы и Советской Гавани
Наука
5 часов назад


